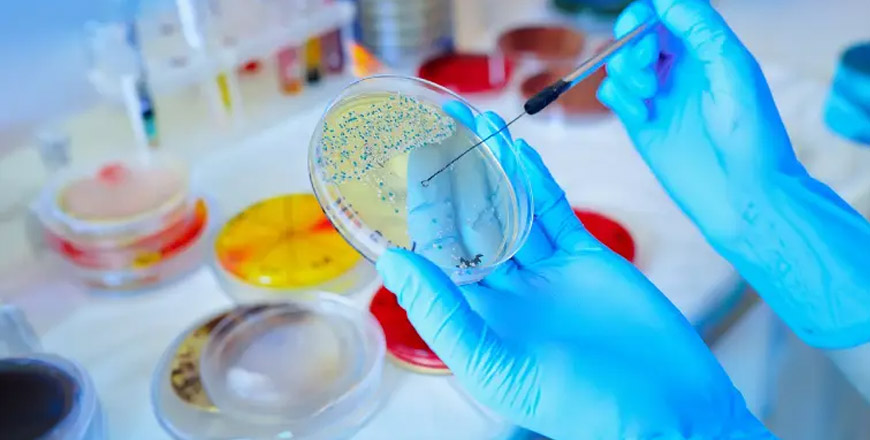

Área Microbiología
Exámenes:
- Urocultivo, recuento De Colonias y Antibiograma
- Coprocultivo
- Flujo Vaginal, Genital o Uretral (Incluye: Directo Al Fresco, Tinción De Gram, Cultivo Corriente y Cultivo De Hongos)
- Cultivo y Antibiograma de Secreciones en General (Nasal, Faríngeo, Ótica, Conjuntival, Heridas, Pus, Respiratorio, Uñas, Etc.)
- Chlamydias Trachomatis
- Mycoplasma – Ureaplasma
- Cultivo De Gonococo
- Streptococcus Grupo B (Perineal)
PREGUNTAS FRECUENTES
¿Qué son los exámenes de microbiología y para qué sirven?
Son pruebas que detectan microorganismos como bacterias, virus, hongos o parásitos en el cuerpo. Se utilizan para diagnosticar infecciones y determinar el tratamiento más adecuado.
¿Qué muestras se utilizan para los exámenes de microbiología?
Dependiendo de la sospecha clínica, se pueden analizar muestras de orina, sangre, heces, secreciones, piel o tejidos. Cada tipo de muestra permite identificar diferentes tipos de infecciones.
¿Cómo debo prepararme para un examen de microbiología?
La preparación depende del tipo de muestra. Por ejemplo, para un urocultivo es necesario recoger la primera orina de la mañana siguiendo instrucciones específicas de higiene. En otros casos, como un hemocultivo, no se requiere preparación especial.
¿Cuánto tiempo tardan los resultados de un examen de microbiología?
Los resultados iniciales pueden estar disponibles en 24 a 48 horas, pero en casos como cultivos bacterianos más complejos, el proceso puede tardar varios días para identificar el microorganismo y determinar su sensibilidad a los antibióticos.
¿Qué sucede si el resultado de un examen de microbiología es positivo?
Un resultado positivo indica la presencia de microorganismos que podrían estar causando la infección. El médico interpretará los resultados y, si es necesario, recetará un tratamiento específico como antibióticos o antifúngicos.
¿Pueden los resultados de microbiología mostrar infecciones resistentes a los medicamentos?
Sí, algunos exámenes, como los antibiogramas, evalúan la resistencia de las bacterias a ciertos medicamentos. Esto ayuda al médico a seleccionar el tratamiento más eficaz para combatir la infección.

55 2 686244